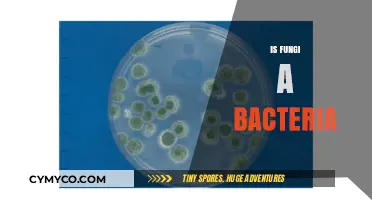
Fungi vs. Bacteria: Unraveling the Differences and Similarities

Fungi are incredibly versatile organisms capable of thriving in a wide range of environments, from the depths of the ocean to the highest mountain peaks. They can grow in diverse habitats, including soil, decaying organic matter, living plants, and even animal hosts. Fungi are particularly adept at colonizing nutrient-rich substrates, such as wood, leaves, and fruits, where they play a crucial role in decomposition and nutrient cycling. Additionally, they can be found in extreme conditions, such as arid deserts, polar regions, and radioactive environments, showcasing their remarkable adaptability. Human-made environments, like buildings and food storage areas, are also susceptible to fungal growth, often leading to issues like mold and spoilage. Understanding where fungi can grow is essential for managing their impact on ecosystems, agriculture, and human health.
| Characteristics | Values |
|---|---|
| Substrates | Soil, decaying organic matter (wood, leaves, dung), living organisms (plants, animals), rocks, and even man-made materials like paper, textiles, and building materials. |
| Moisture | Requires moisture for growth; thrives in damp environments (e.g., humid air, wet surfaces, waterlogged soil). |
| Temperature | Grows in a wide range of temperatures, from cold environments (e.g., Arctic soil) to warm tropical regions, with optimal growth typically between 20°C and 30°C (68°F–86°F). |
| pH Levels | Tolerates a broad pH range but prefers slightly acidic to neutral conditions (pH 5–7). Some fungi can grow in highly acidic or alkaline environments. |
| Oxygen | Most fungi are aerobic, requiring oxygen for growth, though some can grow anaerobically in oxygen-depleted environments. |
| Light | Generally not dependent on light, but some fungi may grow better in low-light or dark conditions. |
| Nutrients | Requires organic nutrients (carbon sources) from their environment, often obtained from dead or decaying matter. |
| Environments | Forests, grasslands, deserts, aquatic ecosystems (freshwater and marine), indoor spaces (e.g., bathrooms, basements), and extreme habitats like hot springs or deep-sea vents. |
| Host Organisms | Can grow on or inside living hosts (plants, animals, humans) as parasites, symbionts, or pathogens. |
| Altitude | Found from sea level to high altitudes, including mountainous regions. |
| Polluted Areas | Some fungi are resilient and can grow in polluted environments, even breaking down toxins. |
Explore related products
What You'll Learn
- Soil and Plant Matter: Fungi thrive in soil, decomposing organic material like leaves, wood, and dead plants
- Indoor Environments: Damp areas like bathrooms, basements, and kitchens often harbor mold and mildew growth
- Food Products: Fungi grow on stored foods, especially bread, fruits, cheese, and grains in humid conditions
- Human and Animal Bodies: Fungi can colonize skin, nails, and mucous membranes, causing infections like athlete’s foot
- Trees and Living Plants: Fungi grow on bark, leaves, and roots, forming symbiotic or parasitic relationships with plants

Soil and Plant Matter: Fungi thrive in soil, decomposing organic material like leaves, wood, and dead plants
Fungi are nature's recyclers, and their role in soil ecosystems is nothing short of vital. They excel at breaking down complex organic materials—leaves, wood, and dead plants—into simpler substances that enrich the soil. This process, known as decomposition, is essential for nutrient cycling, ensuring that elements like carbon, nitrogen, and phosphorus remain available for other organisms. Without fungi, forests and gardens would be buried under layers of undecomposed debris, stifling new growth. Their ability to thrive in soil, even in the absence of light, makes them indispensable in virtually every terrestrial ecosystem.
Consider the forest floor, a prime example of fungi at work. Fallen leaves and decaying logs are not just waste; they are a feast for fungi. Mycelium, the thread-like network of fungal cells, penetrates these materials, secreting enzymes that break down cellulose and lignin—tough plant compounds that most other organisms cannot digest. This activity not only clears the forest floor but also releases nutrients that support the growth of new plants. For gardeners, this means that adding fungal-friendly materials like wood chips or leaf litter can enhance soil fertility naturally, reducing the need for synthetic fertilizers.
However, not all fungi in soil are decomposers. Some form symbiotic relationships with plants, such as mycorrhizal fungi, which colonize plant roots and help them absorb water and nutrients more efficiently. This mutualistic partnership is particularly beneficial in nutrient-poor soils, where plants might struggle to survive on their own. For instance, up to 90% of land plants are estimated to form mycorrhizal associations, highlighting the widespread importance of fungi in plant health. Gardeners can encourage these beneficial fungi by minimizing soil disturbance and avoiding excessive use of fungicides.
Practical tips for harnessing fungi’s soil-enhancing abilities include creating compost piles rich in organic matter, which provide an ideal habitat for decomposing fungi. Adding mushroom compost or inoculating soil with mycorrhizal spores can also boost fungal activity. For woody areas, leaving dead branches and logs to decompose naturally supports fungal growth while providing habitat for insects and other wildlife. Even in urban settings, fungi can be encouraged by using mulch made from shredded leaves or bark, which mimics their natural environment.
In conclusion, fungi’s role in soil and plant matter decomposition is a cornerstone of ecosystem health. By understanding and supporting their activities, we can improve soil fertility, promote plant growth, and contribute to sustainable gardening practices. Whether in a dense forest or a backyard garden, fungi remind us that even the smallest organisms play a monumental role in the cycle of life.
Exploring Fungi: Key Traits, Structures, and Ecological Roles Revealed
You may want to see also
Explore related products
$18.49 $29.99

Indoor Environments: Damp areas like bathrooms, basements, and kitchens often harbor mold and mildew growth
Fungi thrive in environments with excess moisture, making indoor damp areas prime real estate for mold and mildew. Bathrooms, with their frequent water usage and poor ventilation, are particularly susceptible. Showers, bathtubs, and sinks create ideal conditions for fungal growth, especially in grout lines and on shower curtains. Basements, often prone to humidity and water seepage, provide another haven for mold, particularly on walls, floors, and stored items. Kitchens, with their sinks, dishwashers, and cooking activities, can also foster mold growth if not properly maintained.
Identifying Problem Areas: Regularly inspect these zones for signs of moisture accumulation. Look for water stains, peeling paint, musty odors, or visible mold growth. Pay close attention to hidden areas like under sinks, behind appliances, and inside cabinets. Even small leaks can create enough dampness for mold to flourish.
Prevention is Key: Combat mold by controlling moisture levels. Fix leaks promptly, ensure proper ventilation in bathrooms and kitchens, and use dehumidifiers in basements. Wipe down wet surfaces after use, especially in showers and around sinks. Consider using mold-resistant paints and materials in prone areas.
Remediation: If mold is present, address it promptly. For small areas (less than 10 square feet), you can often handle removal yourself. Wear protective gear (gloves, mask, goggles) and use a solution of bleach and water (1 cup bleach per gallon of water) or a commercial mold remover. Scrub the affected area thoroughly and dry completely. For larger infestations or if you have health concerns, consult a professional mold remediation specialist.
Long-Term Maintenance: Regular cleaning and vigilance are crucial. Monitor humidity levels (ideally below 60%) and address any increases promptly. Encourage airflow by opening windows and using exhaust fans. By taking proactive measures, you can create an indoor environment that discourages fungal growth and promotes a healthier living space.
Mold vs. Fungi: Unraveling the Differences and Similarities
You may want to see also
Explore related products
$13.48 $14.13

Food Products: Fungi grow on stored foods, especially bread, fruits, cheese, and grains in humid conditions
Fungi thrive in environments rich in organic matter and moisture, making stored food products prime real estate for their growth. Bread, fruits, cheese, and grains are particularly susceptible, especially in humid conditions. These foods provide the nutrients fungi need to flourish, while humidity accelerates their spore germination and mycelial expansion. A single mold spore, invisible to the naked eye, can quickly colonize a loaf of bread or a piece of fruit, rendering it unsafe to eat within days. Understanding this vulnerability is the first step in preventing fungal contamination in your pantry or refrigerator.
To combat fungal growth on stored foods, consider the storage environment. Bread, for instance, should be kept in a cool, dry place or refrigerated if not consumed within a few days. Fruits, especially those with high sugar content like berries, should be stored in the refrigerator and inspected regularly for signs of mold. Cheese, while naturally hosting beneficial fungi, can still develop harmful molds if exposed to excessive moisture—wrap it in wax or parchment paper rather than plastic, which traps humidity. Grains like rice and flour should be stored in airtight containers to reduce exposure to airborne spores and moisture.
Humidity control is critical in preventing fungal growth. A relative humidity above 60% creates ideal conditions for mold development. Use dehumidifiers in storage areas, especially in kitchens and pantries, to maintain levels below 50%. For small-scale storage, silica gel packets can absorb excess moisture in containers holding grains or dried fruits. Regularly inspect stored foods for early signs of mold, such as discoloration or a musty odor, and discard any contaminated items immediately to prevent cross-contamination.
Comparing storage methods reveals the effectiveness of certain practices. Vacuum-sealed packaging, for example, significantly reduces fungal growth by removing oxygen and moisture, making it ideal for long-term storage of grains and cheese. Conversely, storing bread in plastic bags traps moisture, accelerating mold growth. Traditional methods like salting or fermenting foods (e.g., sauerkraut or miso) inhibit fungal growth by creating an environment hostile to mold while preserving the food. These techniques highlight the importance of tailoring storage methods to the specific needs of each food product.
Finally, education and vigilance are key to minimizing fungal contamination in food products. Teach household members to recognize early signs of mold and the importance of proper storage practices. For example, children over the age of 10 can be taught to inspect fruits for soft spots or unusual colors before consumption. In commercial settings, staff training on humidity control and storage protocols can prevent large-scale spoilage. By combining environmental control, proper storage techniques, and proactive inspection, you can significantly reduce the risk of fungi ruining your stored foods.
Exploring Fungi Reproduction: Methods, Spores, and Life Cycle Secrets
You may want to see also
Explore related products

Human and Animal Bodies: Fungi can colonize skin, nails, and mucous membranes, causing infections like athlete’s foot
Fungi are opportunistic organisms that thrive in diverse environments, and the human and animal body is no exception. Skin, nails, and mucous membranes provide ideal conditions for fungal growth due to their warmth, moisture, and nutrient availability. These areas are particularly susceptible to colonization, leading to infections that range from mildly irritating to severe. Athlete’s foot, for instance, is a common fungal infection caused by dermatophytes, which flourish in the warm, damp environment of feet, especially between toes. Understanding where and how fungi grow on the body is the first step in preventing and treating these infections effectively.
To combat fungal infections, it’s essential to disrupt the environment fungi thrive in. For athlete’s foot, keep feet clean and dry, change socks daily, and avoid walking barefoot in communal areas like locker rooms or pools. Over-the-counter antifungal creams containing clotrimazole or terbinafine can be applied twice daily for 2–4 weeks, depending on the product’s instructions. For nail infections, which are harder to treat, oral medications like terbinafine (250 mg daily for 6–12 weeks) may be prescribed by a healthcare professional. Consistency is key, as premature discontinuation can lead to recurrence.
While humans are often the focus, animals are equally vulnerable to fungal colonization. Pets, particularly dogs and cats, can develop ringworm (despite its name, it’s a fungal infection) on their skin, leading to circular, scaly patches. This infection is zoonotic, meaning it can spread between animals and humans through direct contact or contaminated surfaces. To prevent transmission, isolate infected pets, wear gloves when handling them, and disinfect their living areas with diluted chlorine bleach (1:10 solution). Veterinary treatment typically involves antifungal shampoos or oral medications like itraconazole, administered as directed by a veterinarian.
The mucous membranes, such as those in the mouth and vagina, are also susceptible to fungal overgrowth. Oral thrush, caused by *Candida albicans*, manifests as white patches on the tongue and inner cheeks, often affecting infants, the elderly, or immunocompromised individuals. Antifungal medications like nystatin suspension (5 mL, 4 times daily for 7–14 days) are commonly prescribed. For vaginal yeast infections, clotrimazole suppositories (one applicatorful at bedtime for 3–7 days) are effective. Maintaining a balanced diet, avoiding excessive sugar, and practicing good hygiene can reduce the risk of these infections.
In summary, fungi exploit the body’s warm, moist areas to establish infections that can be uncomfortable and persistent. Prevention hinges on maintaining dryness, cleanliness, and awareness of potential risks. Treatment requires adherence to antifungal regimens, whether topical or systemic, and addressing underlying conditions that may weaken immunity. By understanding the specific vulnerabilities of skin, nails, and mucous membranes, both humans and animals can minimize the impact of fungal colonization and maintain better health.
Exploring Mycology: The Fascinating Study of Fungi and Their Roles
You may want to see also
Explore related products

Trees and Living Plants: Fungi grow on bark, leaves, and roots, forming symbiotic or parasitic relationships with plants
Fungi have an extraordinary ability to colonize trees and living plants, establishing relationships that range from mutually beneficial to outright harmful. On bark, fungi like lichens form a composite organism with algae or cyanobacteria, creating a hardy, symbiotic partnership that thrives in diverse environments, from arid deserts to dense forests. These lichens not only survive but also contribute to nutrient cycling, breaking down complex organic matter into forms plants can use. Conversely, parasitic fungi such as *Armillaria* (honey fungus) invade tree bark, causing decay and often leading to the decline or death of their hosts. This duality highlights the complex interplay between fungi and their plant counterparts.
Leaves provide another fertile ground for fungal growth, often hosting species like powdery mildew or rust fungi. These parasites extract nutrients from living plant tissue, weakening the host and reducing its photosynthetic efficiency. For instance, *Erysiphe cichoracearum* (powdery mildew) forms a white, powdery coating on leaf surfaces, hindering growth and yield in crops like cucumbers and squash. However, not all leaf-dwelling fungi are detrimental; some, like endophytic fungi, live within plant tissues without causing visible harm and may even enhance the plant’s resistance to pests or environmental stress. Understanding these dynamics is crucial for managing plant health in agriculture and horticulture.
Below ground, fungal interactions with plant roots are equally fascinating. Mycorrhizal fungi form symbiotic relationships with roots, extending their network of filaments (hyphae) to increase the plant’s access to water and nutrients like phosphorus and nitrogen. Over 90% of land plants, including trees, rely on these fungi for optimal growth. For example, *Pisolithus arhizus* (dyeball fungus) forms ectomycorrhizal associations with trees like pines, improving their nutrient uptake in nutrient-poor soils. In contrast, root-rotting fungi like *Phytophthora* exploit vulnerabilities in root systems, causing widespread damage in orchards and forests. Practical tips for gardeners and farmers include avoiding overwatering to prevent root rot and using mycorrhizal inoculants to enhance plant vigor.
The balance between symbiosis and parasitism in these relationships underscores the importance of context. For instance, a fungus that benefits a tree in one environment might become parasitic under stress, such as drought or nutrient deficiency. Monitoring fungal activity through soil tests or visual inspections can help identify potential issues early. For young plants (under 2 years old), applying mycorrhizal inoculants at a rate of 1-2 teaspoons per plant during planting can establish a strong root-fungal network. For older trees, mulching with organic matter encourages beneficial fungi while suppressing pathogens. By understanding these interactions, we can foster healthier ecosystems and more resilient plants.
Exploring the Fascinating World of Mycologists: Their Roles and Contributions
You may want to see also
Frequently asked questions
Fungi can grow in damp, humid areas of homes, such as basements, bathrooms, kitchens, and areas with water damage or leaks. They thrive on organic materials like wood, drywall, and carpet.
Fungi grow outdoors in soil, decaying wood, leaves, and other organic matter. They are commonly found in forests, gardens, and areas with high moisture levels.
Fungi can grow on warm, moist areas of the human body, such as the feet (causing athlete’s foot), groin (jock itch), nails (onychomycosis), and skin folds (candidiasis).
Fungi can grow on a variety of foods, especially those that are stored improperly or left in warm, humid conditions. Common examples include bread, fruits, vegetables, cheese, and nuts.
Fungi can grow in industrial settings where there is moisture and organic material, such as in HVAC systems, insulation, paper storage areas, and food processing facilities. Poor ventilation and humidity control contribute to their growth.